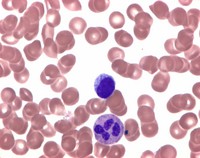
Leishman's eosine methylene blue for microbiology Merck 1013500010

Khách hàng đặt hàng thành công
012345345****
Đang tải...
Hóa chất công nghiệp
Hóa chất & thiết bị thí nghiệm
Khách hàng đặt hàng thành công
012345345****
Khách hàng đặt hàng thành công
1231232132****
Khách hàng đặt hàng thành công
123515345****
Khách hàng đặt hàng thành công
23145324534523****
Khách hàng đặt hàng thành công
234534****
Khách hàng đặt hàng thành công
23453245234****
Khách hàng đặt hàng thành công
3253452****
Khách hàng đặt hàng thành công
q2532453****
Khách hàng đặt hàng thành công
2343****
(0 Đánh giá)
Giá bán 1,233,000đ
Tải về Catalog sản phẩm
Thông tin sản phẩm
Nhận báo giá sản phẩm
Sản phẩm liên quan
Sản phẩm mới
Liên hệ với chúng tôi



Đánh giá